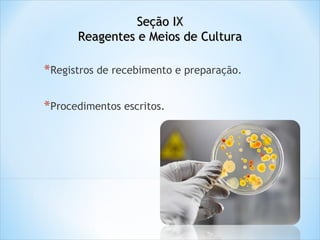
Seção IX
Reagentes e Meios de Cultura

*Registros de recebimento e preparação.
*Procedimentos escritos.

O documento aborda diretrizes para a fabricação de produtos farmacêuticos, destacando a importância da qualidade da água e do controle rigoroso de matérias-primas e materiais de embalagem. Ele estabelece procedimentos para a gestão de produtos reprovados e devolvidos, bem como para o armazenamento e reprocessamento de materiais, com foco na manutenção da qualidade e conformidade. Além disso, menciona a regulamentação e boas práticas necessárias para garantir a segurança e eficácia dos processos industriais.